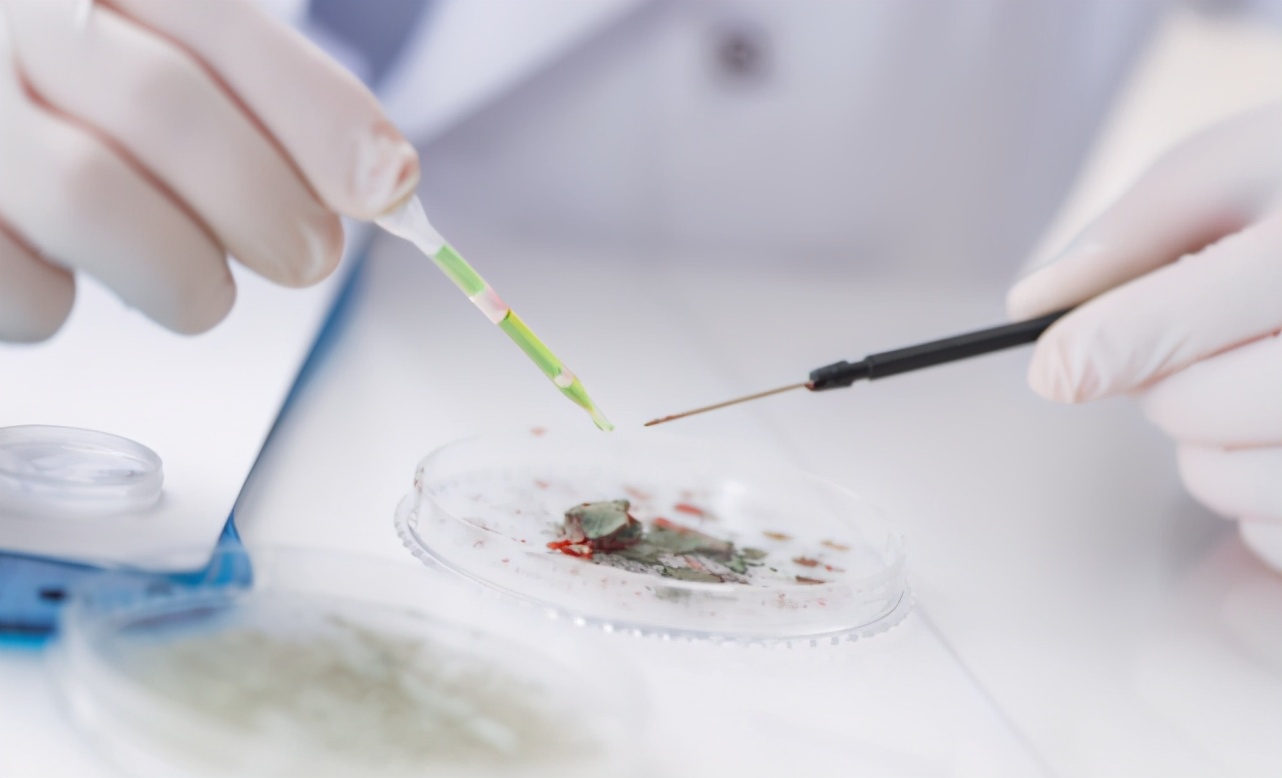
广药三院肿瘤二科｜27岁女孩，查出宫颈癌，连续交往多个男友

近年来,宫颈癌频发,并且“魔爪”伸向了年轻女性。

27岁的小芳,在单位体检时,被告知有宫颈病变,建议做进一步检查。
小芳同意了,本想着自己年轻,不会有啥大问题,做检查权当是求个心里安慰,却不料,最终检查结果被确诊为宫颈原位癌,不得不实施宫颈切除手术。

这样的结果,小芳一时间懵掉了,自己还没结婚,考虑自己平时的行为,这消息不太敢告诉父母,只是和闺蜜朋友说了。
当闺蜜知晓后,虽然也感到吃惊,但还是凑了钱,让小芳先进行了手术。
可从此,小芳永远丧失了生育能力,这样的结果,让朋友感叹:不值得啊~
原来,小芳是一名都市女白领,与男友是青梅竹马。
可没成想,男友想要出国深造,两人就此断了十几年的感情。
在感情受挫后,小芳便不断的更换男友,想以此来寻找心理的慰藉。
几年来,小芳和多个男子发生过关系,先后患过淋病和尖锐湿疣,也得过阴道炎和泌尿系统感染等妇科病,但她一直没有重视,每次治疗后依然重蹈覆辙。

为此,小芳的朋友没少劝她,不该因为一个男人,而这样放纵自己,女人要先学会自爱,才会有人爱。
可每次小芳都只是听听就算了,从未放在心上,却怎么也没想到,会是这样的结果。
哪些女性,容易被宫颈癌找上?
一、感染病毒者

首当其冲的就是病毒感染者。
医学表明,高危型HPV持续感染是宫颈癌的主要危险因素。
90%以上的宫颈癌伴有高危型HPV感染。
二、早尝“*果禁**”者
早尝“*果禁**”者,即20岁以前发生关系者,宫颈癌高发。
这些女性患宫颈癌的危险度,是20岁前无*生活性**女性的6倍。

三、多次妊娠者
女性多次妊娠,也是宫颈癌的原因之一。
宫颈癌的发生率,随妊娠次数的增加而递增。
生育7胎以上的女性,比生育1~2胎的女性,宫颈癌发生率高10倍以上。

四、吸烟者
吸烟女性和戒烟女性,宫颈癌的发病率,比从不吸烟的女性分别高出1.7%和0.7%,女性吸烟越多,宫颈癌的发病率越高。

女性出现三种异常,小心宫颈癌找上门
一、白带异常
白带,是女性身体健康的“晴雨表”。
宫颈癌最常见的症状之一,就是白带异常。
白带增多、白带伴随血丝状、白带气味变化等,都要注意。
二、事后出血
如果每次事后,都会莫名的出血,最好第一时间就诊查明原因。

三、小腹隐痛、下腹疼痛
宫颈出现癌变,压迫到子宫神经,便会引起疼痛。
因此,出现下腹隐痛、下腹疼痛等问题,最好到医院检查一下宫颈。
女人自爱,预防宫颈癌,做好这五点,很重要

一:消炎杀菌,常饮茶
慢性炎症,与细胞癌变,有协同致癌作用。
而女性生理结构特殊,易出现炎症,导致免疫能力变差。
因此,女性要积极预防改善炎症,但不要滥用抗生素,以免产生抗药性。
生活中,可以多喝茶水养生

二、强健免疫,做运动
免疫力,是抵抗疾病的“盾牌”。
适当的运动,可以增强免疫力,提高女性对抗病毒的能力。
一旦免疫功能低,易受到各种病毒或细菌感染,从而导致宫颈部位发生病变。
建议每周至少保持30分钟的有氧运动,能大幅降低患子宫颈癌的风险。
慢跑、快走、游泳、瑜伽等,都是不错的运动方式。

三、控制情绪,不生气
百病皆有气生,长期生气,伤身损命。
生活中,女性往往容易生气,情绪波动较大。
如果,恼怒超过半年不解,大约要缩短2~3年寿命。
并且,女性长期生气,情绪低落,会增加罹患癌症的风险。
所以,女性一定要格外注意,控制好自己的情绪,尽量少生气发怒。
即便是生气,最好也不要超过3分钟,可以做一些自己喜欢的事情来转移注意力。

四、注意个人卫生
保持卫生,是预防妇科疾病的重要步骤之一。
每天更换*裤内**,千万不要过度的清洗,不要乱用洗液,以免产生耐药性。
清洗*裤内**,最好是单独清洗,并且在太阳下晾晒,每3个月更换一次。
避免经常穿紧身裤,长期的密闭环境,很容易滋生细菌,病毒,形成炎症,宫颈癌等。

五、注射疫苗,降低风险
宫颈癌高发,首当其冲的就是病毒感染。
医学表明,高危型HPV持续感染是宫颈癌的主要危险因素,90%以上的宫颈癌伴有高危型HPV感染。
注射疫苗,可降低70%的宫颈癌发病率。

广东药科大学附属第三医院住院部二楼